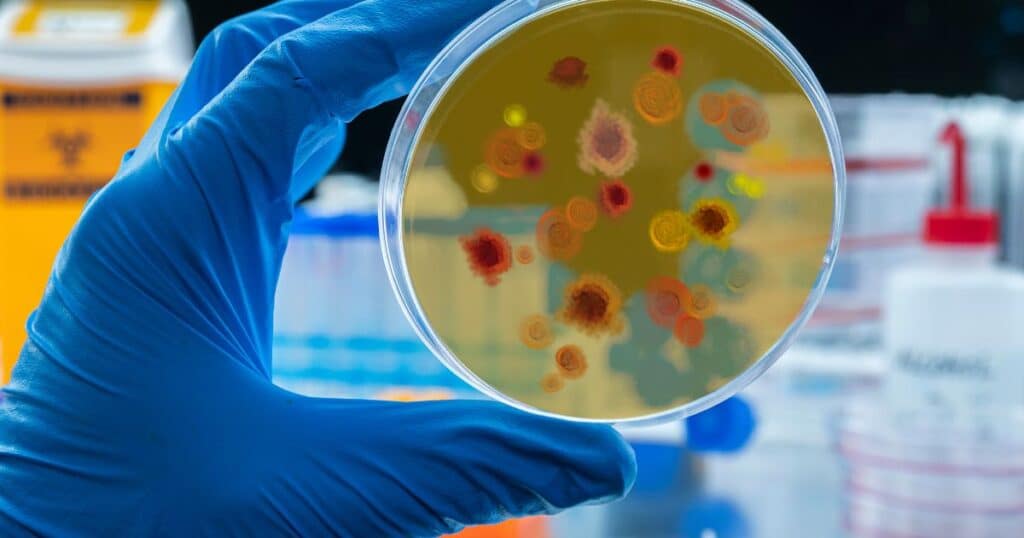

A dengue outbreak can be a serious concern, especially in areas with stagnant water where mosquitoes breed. A cleaning service can play a critical role in preventing and managing the spread of dengue by targeting areas where mosquitoes might thrive. Here’s how a cleaning service can help reduce the risks of an outbreak:
Dengue Outbreak: Mosquito Breeding Grounds Identification & Elimination
- Inspection and Removal of Standing Water: The most significant way to combat the spread of dengue is by eliminating standing water, as it provides an ideal breeding ground for mosquitoes. Avoiding mosquito bites is a crucial preventive measure in reducing the risk of dengue infection. Cleaning services can inspect areas such as clogged gutters, water storage containers, flower pots, and other places where water may accumulate, and either clean or drain them. Minimizing exposure to mosquito bites significantly lowers the likelihood of contracting this viral infection.
- Proper Drainage Systems: The cleaning team can ensure that drainage systems are clear of debris to prevent water from collecting and stagnating, especially in areas prone to flooding.
1.1 Understanding Mosquito-Borne Diseases

1.2 Understanding Dengue Fever

Dengue fever is a complex and multifaceted disease that requires a comprehensive understanding of dengue cases, its causes, symptoms, and transmission dynamics. The disease is caused by the dengue virus, which is transmitted through the bites of infected mosquitoes. There are four distinct but closely related dengue viruses (DENV-1, DENV-2, DENV-3, and DENV-4), each capable of causing dengue cases with a range of symptoms, from mild to severe.
Severe dengue, also known as dengue hemorrhagic fever, is a life-threatening condition that requires immediate medical attention. It is characterized by severe stomach or abdominal pain and, vomiting, difficulty breathing, and bleeding from the nose, gums, or gastrointestinal tract. Understanding the causes and symptoms of dengue fever is crucial for effective prevention and control measures. By recognizing the warning signs of dengue early and taking appropriate action, individuals can help reduce the risk of severe complications and improve outcomes.
1.3 Symptoms and Diagnostics

The symptoms of dengue fever can vary widely, ranging from mild to severe. Common symptoms include high fever, headache, body aches, nausea, and rash. In some serious dengue fever cases reported, these mild symptoms may be mistaken for other illnesses, such as the flu. Severe dengue symptoms often emerge after the fever has subsided and can include severe stomach pain, vomiting, difficulty breathing, and bleeding.
Diagnosing dengue fever can be challenging, as the symptoms are similar to those of other diseases. Blood tests are available to confirm the diagnosis, including detecting viral RNA or antibodies to the virus. Early diagnosis and treatment spread dengue fever, are critical for preventing severe complications and reducing the risk of death. By being aware of the symptoms and seeking medical attention promptly, individuals can help manage the disease more effectively.
1.4 Transmission and Risk Factors

Dengue fever is transmitted through the bites of infected mosquitoes, primarily the Aedes aegypti mosquito. The virus can also be transmitted from a pregnant mother to her child. Previous infection with one of the dengue viruses increases the risk of developing a severe form of dengue upon subsequent infections with a different strain. Urbanization, particularly unplanned urbanization, is associated with increased risk of dengue transmission due to factors such as poor sanitation and crowded living conditions.
Community risks to dengue also depend on a population’s knowledge, attitude, and practice towards dengue prevention. Routine vector surveillance and disease control activities that engage the community can greatly enhance a community’s resilience. Vectors may adapt to new environments and climate, and disease risks may change and shift with climate change in tropical and subtropical areas. Understanding these risk factors is essential for implementing effective prevention and disease control, measures.
1.5 Identifying Mosquito Breeding Grounds

Mosquitoes that transmit dengue fever breed in standing water, which can be found in a variety of locations, including:
- Flowerpots and vases
- Bird baths and pet water dishes
- Clogged drains and gutters
- Buckets and containers
- Tree holes and rock crevices
Identifying and eliminating mosquito breeding grounds is critical for preventing the spread of dengue fever. This can be done by regularly inspecting and removing standing water around homes and public areas. Using mosquito traps and larvicides can also help reduce mosquito populations. Implementing integrated vector management (IVM) strategies, which combine multiple methods to control mosquito populations, is another effective approach. By taking these steps, communities can significantly reduce the risk of dengue transmission.
1.6 Eliminating Mosquito Breeding Grounds

Eliminating mosquito breeding grounds requires a comprehensive approach that involves the community, public health officials, and individuals. Some effective ways to eliminate mosquito breeding grounds include:
- Using mosquito traps and larvicides
- Implementing IVM strategies
- Eliminating standing water around homes and public areas
- Using mosquito nets and air conditioning
- Wearing protective clothing and applying insect repellent
Preventing mosquito bites is critical for preventing the spread of dengue fever. This can be done by avoiding mosquito bites, especially during the day when Aedes mosquitoes are most active. Wearing protective clothing, applying insect repellent, staying in air-conditioned or screened areas, and using mosquito nets are all effective measures. By taking these precautions, individuals can protect themselves and their communities from dengue fever.
1.2 Identifying Mosquito Breeding Grounds
Mosquitoes require standing water to breed, making the identification of potential breeding grounds essential for preventing the spread of mosquito-borne diseases. Common mosquito breeding grounds include:
- Standing Water Around Homes: Pet water dishes, flower vases, and clogged drains can all serve as breeding sites.
- Natural Bodies of Water: Ponds, lakes, and marshes are natural habitats where mosquitoes can thrive.
- Artificial Containers: Buckets, tires, and bird baths can collect water and become breeding grounds.
- Areas with Poor Drainage: Flooded streets and alleys can create stagnant water pools ideal for mosquito breeding.
By identifying and addressing these breeding grounds, individuals can significantly reduce the risk of mosquito-borne diseases in their communities.
1.3 Eliminating Mosquito Breeding Grounds
Eliminating mosquito breeding grounds is a crucial step in preventing the spread of mosquito-borne diseases. Here are some effective strategies:
- Remove Standing Water: Regularly empty containers, fix clogged drains, and use mosquito-killing granules to eliminate standing water around homes.
- Use Mosquito Traps: Deploy mosquito traps or mosquito-killing devices in areas with high mosquito activity to reduce their population.
- Integrated Vector Management (IVM): Implement IVM strategies, which combine multiple methods to control mosquito populations effectively.
- Apply Mosquito Repellents: Use mosquito repellents or insecticides in areas with high mosquito activity to protect against bites.
By taking these steps, individuals can help reduce the risk local transmission of mosquito-borne diseases and safeguard their communities.
The Dengue Virus and Dengue Fever
The dengue virus is a type of flavivirus responsible for causing dengue fever, a mosquito-borne disease. There are four closely related dengue viruses (DENV-1, DENV-2, DENV-3, and DENV-4), all of which are transmitted through the bite of an infected mosquito. The dengue virus is a significant public health concern worldwide, particularly in tropical and subtropical regions.
The dengue virus can cause a range of symptoms, from mild to severe, including a high fever throughout, headache, joint pain, and rash. In severe cases, the dengue virus infection can lead to a condition called dengue hemorrhagic fever, characterized by severe bleeding and organ failure. Understanding the nature of the dengue virus and its transmission is essential for effective prevention and control measures.
1.5 Global Burden of Mosquito-Borne Diseases

Mosquito-borne diseases, such as dengue fever, represent a significant public health challenge globally. According to the World Health Organization (WHO), there are over 390 million dengue cases reported annually, resulting in over 96 million cases of illness and approximately 22,000 deaths. Severe cases of dengue fever, called severe dengue, can lead to life-threatening complications such as shock, internal bleeding, and organ failure.
The global burden of mosquito-borne diseases is particularly severe in tropical and subtropical regions, where these diseases can cause widespread illness, death, and economic hardship. Addressing this burden requires coordinated efforts in prevention, control, and public health education.
1.6 Climate Change and Mosquito-Borne Diseases

Climate change is a significant factor in the spread of mosquito-borne diseases, such tropical diseases and dengue fever. Rising temperatures and changing precipitation patterns create environments more conducive to the proliferation of mosquitoes.
Climate change can expand the range and increase the abundance of mosquitoes, allowing them to thrive in new areas. This can lead to a rise in mosquito-borne diseases, particularly in regions with inadequate public health infrastructure. By understanding the impact of climate change on local transmission of mosquito-borne diseases, communities can take proactive steps to mitigate these effects and protect public health. The dengue vaccine can help mitigate the impact of climate change on the spread of dengue fever by providing immunity to the population.
Regular Cleaning of Public Areas and Avoiding Mosquito Bites

- Common Areas: If the outbreak is in a community, office building, or apartment complex, cleaning services can conduct regular cleaning of common areas (like lobbies, elevators, and outdoor spaces). Regularly removing trash and leaves from these areas helps prevent stagnant water buildup.
- Disinfecting Surfaces: While mosquito prevention is the primary focus, disinfecting surfaces in areas where people gather can help limit the spread of other diseases that may coincide with a dengue outbreak.
3. Spraying and Fogging Services

Mosquito Control Sprays: Cleaning services can also offer mosquito control spraying or fogging treatments. These can be applied to areas where mosquitoes are most likely to inhabit, such as gardens, courtyards, and areas surrounding buildings. These treatments help kill adult mosquitoes. for dengue infection prevention Additionally, mosquito control sprays help reduce the other risk factors of dengue infection by targeting mosquito populations.
Insect Repellent: Services can supply insect repellent to residents or businesses during the outbreak, encouraging everyone to protect themselves from mosquito bites themselves.
4. Public Awareness & Education

- Flyers & Posters: In places like schools, hospitals, and communities, cleaning services can help distribute materials that educate the public about the importance of mosquito control, personal protection, and how to eliminate breeding grounds. Additionally, these materials should emphasize the importance of recognizing the symptoms of dengue and seeking medical attention.
- Staff Training: The cleaning team can be trained in recognizing areas conducive to mosquito breeding, enabling them to be proactive in addressing potential risks. Training should also include information on treating pain symptoms in dengue fever management, highlighting the use of acetaminophen for pain relief while avoiding non-steroidal anti-inflammatory drugs.
5. Safe Disposal of Waste

- Proper Waste Disposal: In areas with high mosquito activity, improper waste disposal can contribute to water stagnation. Cleaning services can ensure that waste is disposed of correctly to avoid potential breeding grounds.
Global Burden of Mosquito-Borne Diseases and Dengue Prevention

Partnership with Local Authorities: Cleaning services can partner with local public health workers and departments to ensure that their efforts align with government initiatives to combat the outbreak. This partnership can also help with timely reports of any issues related to mosquito breeding.
By taking proactive steps to prevent infection like these, cleaning services can help to significantly reduce the risk of severe dengue outbreaks and provide communities with a cleaner, safer environment. Collaboration with health authorities is crucial in managing severe dengue cases and preventing dengue shock syndrome, which can lead to severe complications such severe symptoms as internal bleeding, organ damage, and potentially death.
Book a Cleaning Today!

Don’t wait for mosquitoes to become a problem—take action now! Whether it’s a one-time deep clean or regular maintenance, Happy Housekeepers is here to help keep your environment safe and clean.
